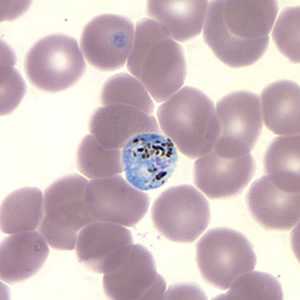
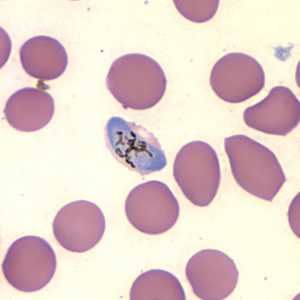
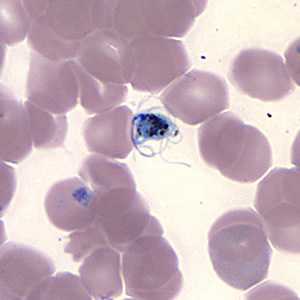

Case #157 - June, 2005
A 25-year-old woman with symptoms of intermittent fever, nausea, and headaches went to the emergency room with a temperature of 104º. She had worked and traveled in West Africa for the previous five months. Although she had taken antimalarial drugs while she was abroad, she ceased prophylaxis when she returned to the United States. While at the emergency room, the attending physician ordered a blood smear, which was stained with Wright-Giemsa and examined. Figures A-F show what was observed on the thin smear at 1000× magnification. What is your diagnosis? Based on what criteria?

Figure A
Figure B
Figure C

Figure D

Figure E
Figure F
Case Answer
The was a case of malaria caused by Plasmodium falciparum. Diagnostic features included:
- rings that were mostly thin and delicate (Figure A), although this area of the smear is less than ideal due to overlapping red blood cells. There appears to be one late ring or early trophozoite state in this image as well.
- a rounded gametocyte in a more or less normal-sized RBC (Figure B). The surrounding RBC’s vary somewhat in size and shape, so an accurate assessment of the infected RBC is difficult.
- typical crescent or banana-shaped gametocytes (Figures C and D), consistent with P. falciparum. Note that the pigment is centrally located.
Figures E and F are remarkable because they show gametocytes undergoing exflaggellaton. Some of the same blood that the smears were made from was also sent to CDC and PCR analysis was performed. Only P. falciparum was identified by the PCR test. It was later confirmed by the County Health and Human Services that the submitting laboratory did not make smears in a timely manner and that the blood was held on the bench at room temperature for a few hours. This case demonstrates the need to prepare blood smears immediately after blood collection to prevent unusual morphologic presentation of parasites in the specimen.
More on: Malaria
This case was kindly contributed by the San Diego County Health and Human Services.
Images presented in the monthly case studies are from specimens submitted for diagnosis or archiving. On rare occasions, clinical histories given may be partly fictitious.
DPDx is an education resource designed for health professionals and laboratory scientists. For an overview including prevention and control visit www.cdc.gov/parasites/.
- Page last reviewed: August 24, 2016
- Page last updated: August 24, 2016
- Content source:
- Global Health – Division of Parasitic Diseases and Malaria
- Notice: Linking to a non-federal site does not constitute an endorsement by HHS, CDC or any of its employees of the sponsors or the information and products presented on the site.
- Maintained By:


 ShareCompartir
ShareCompartir